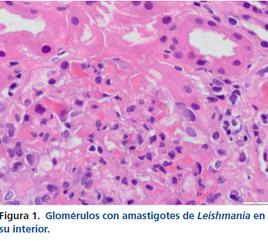

LEISHMANIA EN PACIENTE CON
INFECCION POR EL VIH Y EL VHB NO
CONOCIDA






Integrantes:
Julieth Tatiana Cortes
Jessica Paola Sánchez Camargo
Adriana Marcela Andrade Cárdenas
Edgar Adalber Blanco Barrera
Jhojan David Moreno Apraez
Grupo: 151006 _ 158
Microorganismos y su relación clínica asociada.

2. Triada Epidemiológica.
3. Estudios realizados al paciente para el diagnóstico y explicación de los más relevantes en el caso clínico.


4. Tratamientos realizados al paciente y explicación de los más relevantes en el estudio.
5. Datos epidemiológicos a nivel nacional con los microorganismos del caso más relevantes.



6. Referencias Bibliográficas.

Fuente: National Library of Medicine. (s. f.-b). Hepatitis B. https://medlineplus.gov/spanish/he patitisb.html

Fuente: Album. (s. f.). Leishmania donovani,LM-alb10616383albumonline.com. Album. https://www.albumonline.com/detail/es/YTE3MzhhMA/l ight-micrograph-leishmaniadonovani-important-cause-diseaseleishmaniasis-brightfieldmagnification-alb10616383?
sT=UNICELLULAR+PROTIST&iSF=3

Fuente:Tttigres.(2022,11febrero). Citomegalovirus (CMV): ¿Qué es?, ¿cómo se transmite?, ¿cuáles son sus síntomas?, ¿cómo tratarlo? Instituto Bernabeu – Clínicas de Reproducción Asistida. https://www.institutobernabeu.com /es/foro/citomegalovirus-cmv-quees-como-se-transmite-cuales-sonsus-sintomas-como-tratarlo/

Fuente:Brazier,Y.(2021,25agosto). Síntomas, causas y tratamiento para el herpes. https://www.medicalnewstoday.co m/articles/es/323873

Fuente: Fundacion iO. (2020, 17 diciembre).StaphylococcusaureusFundación iO. Fundación iO. https://fundacionio.com/saludio/enfermedades/bacterias/staphyl ococcus-aureus/
VHB (virus de la hepatitis B): Es un virus que ataca y produce inflamación en el hígado lo que puede inducir la presencia de un síndrome nefrótico llegando a causar nefropatía en el paciente.
leishmaniasis Donovani: Es una enfermedad grave que afecta el bazo, hígado y otros órganos internos ya que es potencialmente mortal siendo oportunista en el huésped.
Cmv (citomegalovirus): Es un virus común que afecta a todas las personas que puede ocasionar hepatitis debido a que debilita el sistema inmunitario en el citomegalovirus llegando hacer grave.
VHS1(Herpes virus tipo 1): Es un virus contagioso que causa infecciones en la boca que en paciente inmunosuprimidos puede desencadenar complicaciones más graves.
Staphylococcus aureus: Es una bacteria común que vive en la nariz y en la piel de muchas personas ,empeora la función renal progresivamente y provoca sedimento urinario activo.
Es una infección oportunista con rápida progresión potencialmente mortal ataca a pacientes inmunodeprimidos.
Se constata coinfección por el VIH ( Virus de la inmunodeficiencia humana) VHB(Virus hepatitis B, y finalmente la leishmaniasis (Parasito diseminado por la picadura de un mosquito) visceral o la enfermedad de kala-azar

la cual es la responsable de la afectación renal y el empeoramiento de las manifestaciones clínicas.
La leishmaniasis es una enfermedad oportunista poco frecuente en los pacientes con VIH, lo que dificultó el diagnóstico hasta que se realizó la biopsia de médula ósea y renal.
Ante un paciente con pancitopenia, hepatoesplenomegalia y fiebre se debe tener en cuenta la patología producida por Leishmania. Si no se conocen sus antecedentes clínicos previos, hay que sospechar enfermedades que condicionen inmunosupresión.
1.AGENTECAUSAL
La hepatitis es una inflamación del hígado Puede ser causada por una variedad de toxinas (como drogas o alcohol), enfermedades autoinmunes o patógenos (incluidos virus,bacteriasoparásitos)
con agujas o transfusiones de sangrecontaminada. Transmisióndemadreahijo:
El VHB se puede transmitir de una madre infectada a su hijo durante el embarazo, el parto olalactanciamaterna

Familiadevirus: Hepadnaviridae
Género: Orthohepadnavirus
Especie:Virusdela HepatitisB

Contacto sexual: El VHB se puede transmitir a través del contactosexualconunapersona infectada
Contactoconsangre: El VHB se puede transmitir a través del contacto con sangre infectada, comopinchazosaccidentales
2.HUESPED SUSCEPTIBLE
Elserhumanoeselúnicohuésped natural del VHB El virus infecta principalmente las células del hígado,llamadashepatocitos.
3AMBIENTEO RESERVORIO
El VHB se transmite a través del contacto con sangre, semen y otros fluidos corporales infectados. Las principalesvíasdetransmisiónson:
FUENTE: Autoría propia, Bogotá mayo 2024
1.AGENTECAUSAL
Es una bacteria común que vive en la nariz y en la piel de muchas personas sanas, sin causar ningún problema Sin embargo, bajo ciertas circunstancias, puede invadir el organismo y provocar infeccioneslevesograves


Familiadevirus:
Staphylococcaceae
Género:Staphylococcus
Especie: Staphylococcus aureus


El huésped es su reservorio principal, Staphylococcus aureus también puede sobrevivir por períodos cortos en el ambientebajociertascondiciones:
Superficiescontaminadas Polvo Aguayalimentos
2HUESPED SUSCEPTIBLE
Es una bacteria que puede vivir en diferentes huéspedes, principalmente vertebrados personas y animales Si bien puede colonizar a estos huéspedes sin causar daño, también tiene la capacidad decausarunavariedaddeinfecciones
3AMBIENTEO RESERVORIO
Staphylococcus aureus es un colonizador habitual de la piel y la nariz depersonasyanimalessanos
El patógeno de la leishmaniasis es un protozoo parásito del género Leishmania que se transmite por la picadura de flebótomos hembra infectados

Familiadevirus:
Trypanosomatidae
Género:Leishmania
Especie:Leishmania donovani

Las condiciones ambientales juegan un papel importante en la supervivencia y transmisión del parásito La Leishmaniasis Donovani es más prevalente en zonas tropicales y subtropicales con climas cálidosyhúmedos,quesonhábitats favorablesparalosflebotomos
2.HUESPED SUSCEPTIBLE
Principalmente seres humanos, aunque también puede infectar a perros y otros mamíferos Estos huéspedes actúan como reservoriosdelparásito
3.AMBIENTEO RESERVORIO
Flebotomos hembras del género Phlebotomus Estos insectos actúan como vectores que transmiten el parásito de un huésped vertebrado infectadoaotrosusceptible
FUENTE: Autoría propia, Bogotá mayo 2024
1AGENTECAUSAL
eselvirusherpeshumano5(HHV-5), perteneciente a la familia
Herpesviridae Es un virus ADN de gran tamaño, con una cápside icosaédricayunaenvolturaexterna
El virus también puede sobrevivir temporalmente en el ambiente bajo ciertas condiciones No se considera que el ambiente sea un reservorio a largoplazo
Superficiescontaminadas
Polvo
Aguayalimentos

Familiadevirus:
Herpesviridae
Género: Cytomegalovirus
Especie:Human herpesvirus5(HHV-5)

Sin embargo, puede permanecer latente en el cuerpo y reactivarse ocasionalmente, causando problemas en personas con sistemas inmunitarios debilitados
También puede infectar a una amplia variedad de animales (perros, gatos, ganado, etc) y salvajes (primates no humanos,roedores,marsupiales)
2.HUESPEDSUSCEPTIBLE
conocido como herpesvirus humano 5 (HHV-5),tienecomohuéspedprincipalalos humanos Se estima que entre el 50% y el 90%delosadultosenelmundohanestado encontactoconelvirusenalgúnmomento de su vida La infección por CMV suele ser asintomática o presentar síntomas leves similaresalamononucleosisinfecciosa
3.AMBIENTEO RESERVORIO
El CMV se considera un virus oportunista, lo que significa que generalmente no causa enfermedades en personas con un sistemainmunitariosano
1AGENTECAUSAL
El agente causal del Herpes virus tipo 1 (VHS-1) es el virus del herpes simple tipo 1 Es un virus perteneciente a la familia
Herpesviridae
La transmisión del VHS-1 a través del ambiente es menos frecuente que el contacto directo, pero puede ocurrir por contacto con objetoscontaminadoscomo: Tollas
Utensilios
Objetosdeusopersonal
Familiadevirus:
Herpesviridae
Género:Virusdel herpestipo1
Especie:Simplexvirus1

El VHS-1 no se replica en el ambiente, puede sobrevivir temporalmente en algunas superficies, especialmente en ambienteshúmedosyatemperatura ambiente
2.HUESPED SUSCEPTIBLE
El virus de tipo 1 (VHS-1) se propaga mayoritariamente por contacto bucal y causa infecciones en la boca y zonas contiguas (herpes labial o pupas o calenturas labiales) También puede causar herpes genital La mayoría de los adultosestáninfectadosporelVHS-1.
3.AMBIENTEO RESERVORIO
El VHS-1 se encuentra principalmente en las células nerviosas ganglionares de la cara, específicamenteenelgangliotrigeminal el virus puede reactivarse y viajar por las neuronashastalapiel,causandounbrotede herpeslabialuotraslesiones
FUENTE: Autoría propia, Bogotá mayo 2024

Este caso es de un varón de 40 años de raza negra, no presenta antecedentes familiares conocidos, entre sus antecedentes personales se destacan el consumo previo de cocaina y habito tabáquico hasta hace 1 año sin tratamiento.
El paciente consulta por urgencias por malestar general, epistaxis leve autolimitada, astenia, nauseas, vómitos de contenido alimenticio y sensación febril.
Se realizan los siguientes procedimientos diagnósticos al ingreso:
Signos vitales.
Prueba de examen analítica.
Examen de orina.
Radiografía de tórax: Índice cardiotorácico normal, hilios engrosados con adenopatías calcificadas. Silueta cardio mediastínica y parénquimas sin otros hallazgos.
Prueba rápida de malaria: Negativa.
Ecografía abdominal: Riñones de tamaño agrandado (14 cm) y eco estructura normal. No presenta ectasia pielocalicial. Hay esplenomegalia de 18 cm, con probables hemangiomas esplénicos y hepático.
Tomografía por emisión de positrones-tomografía computarizada: moderada captación difusa en ambas glándulas parótidas sugerente de proceso inflamatorio, infeccioso, autoinmune, etc.
Presenta adenopatías latero cervical derecha y mediastínicas hipermetabólicas, baja captación difusa en ambos parénquimas pulmonares y esplenomegalia con incremento metabólico difuso, todo ello sugerente de proceso reactivo/inflamatorio. Hay disminución de la captación renal bilateral compatible con insuficiencia renal. No hay otros hallazgos indicativos de lesiones neoplásica.

Ecocardiograma: hipertrofia concéntrica grave del ventrículo izquierdo con fracción de eyección del ventrículo izquierdo conservada
A continuación, se presenta el informe de la biopsia renal.

Estudios de Imagenología Renal: Se podrían realizar ecografías, tomografías computarizadas (TC) o resonancias magnéticas (RM) para evaluar el estado estructural y funcional de los riñones, buscando signos de inflamación, daño o complicaciones como hidronefrosis o formación de abscesos.
Biopsia Renal: En casos graves o cuando los resultados de otros estudios no son concluyentes, se podría realizar una biopsia renal. Esto implica tomar una muestra de tejido renal para examinarla bajo el microscopio y obtener información detallada sobre el tipo y la gravedad del daño renal.


Descripción microscópica (figs. 1 y 2): media de 12 glomérulos con expansión mesangial e irregular incremento de la celulari-dad. Se observa leve hiperplasia e hipertrofia podocitaria, así como múltiples oquedades en cortes tangenciales de la membrana basal, observadas con plata metanamina. En algunos de los glomérulos se observan amastigotes de Leishmania

Microscopia electrónica (fig. 3) Presencia de algunos depósitos electróndensos granulares a nivel intramembranoso, subendotelial y en el mesangio. Fusión pedicelar focal. Alteraciones compatibles con afectación renal por LV de patrón membranoproliferativo.


Biología molecular Análisis molecular del ADN extraído de la biopsia renal. Detección del gen TOP2 de Leishmania (donovani/infantum) mediante el kit RealCycler DONO (BioRad). Control de amplificación: positivo. Asimismo, dado el grado de afectación hematológica, se realiza también biopsia de medula ósea (v. fig. 3; fig. 4). Se evidencian abundantes histiocitos con amastigotes de Leishmania en su interior, imágenes de hemofagocitosis y áreas de degeneración mucinosa del estroma. Se observa plasmocitosis policlonal. El análisis molecular del ADN extraído del extendido de aspirado de médula ósea detecta el gen TOP2 de Leishmania.


DENTIFICACION COMPLICACIONES TERAPIA POR INFECCIONES BACTERIANAS
El paciente es tratado con Daptomicina por presentar en su hemocultivo Staphylococcus aureus sensible a la meticilina. Este es un antibiótico utilizado para tratar infecciones graves, en su mecanismo de acción está indicado para infecciones complicadas de piel y partes blandas, endocarditis infecciosa del lado derecho (EID) debida a Staphylococcus aureus.
TERAPIA CON ANTIMICROBIANOS E INMUNOSUPRESOR
Se inicia tratamiento con antirretroviral con Anfotericina B liposomal, con mejoría progresiva, ya que este medicamento antifúngico es utilizado en el tratamiento de infecciones graves por hongos especialmente la Leishmaniasis visceral y antirretroviral para el VHI.
TERAPIA MANEJO DE INSUFICIENCIA RENAL
Función renal empeora progresivamente, con sedimento urinario activo su función renal inicialmente mejora hasta 1,2 mg/ dl de creatinina, a la semana de tratamiento se objetiva un empeoramiento de su creatinina hasta 1,8 mg/dl, que es atribuido a la nefrotoxicidad tubular del fármaco, esto se entiende qué puede dañar directamente los túbulos renales lo que obliga a reducir la dosis.
TERAPIA APOYO CON MEDICAMENTOS PARA HIPERTENSION
Al dar de alta al paciente se continua con su tratamiento ambulatorio con anfotericina B liposomal de manera semanal.

Se asocian a su terapia antihipertensiva con 2 fármacos, incluyendo antagonistas de los receptores de la angiotensina II que son utilizados para regular la presión arterial alta los ARA relajan los vasos sanguíneos y continua con terapia antirretroviral.
Finalmente se suspende el tratamiento con anfotericina B liposomal al mes de inicio del tratamiento por deterioro en la función renal.
El paciente continua su tratamiento con Miltefosina este es un fármaco que tiene propiedades antineoplásicas, inmunomoduladores, antivirales y anti protozoarias. Esta indicado para el tratamiento de la leishmaniosis visceral por vía oral en dosis de 100 a 150 mg/ día con un porcentaje de curación del 98%. Con una función renal estabilizada de creatinina (1,4 mg/dl) y filtrado glomerular de 61 ml/min.
Concluimos que en el tratamiento del paciente como el uso de los medicamentos antirretrovirales nos ayudan a presentar una mejoría clara del estado general, esto sugiere que esta siendo efectivo en el manejo por la infección por VIH.
El tratamiento con el medicamento anfotericina B liposomal presenta mejoría, pero la administración se debe realizar en dosis bajas para disminuir la nefrotoxicidad tubular del fármaco.
Finalmente, el paciente queda formulado con la Miltefosina para seguir el manejo de su patología, es de gran importancia seguir con las indicaciones médicas y monitorear de cerca la función renal durante el tratamiento.

nacional con los microorganismos del caso más relevantes.
Leishmaniasis cutánea: Hasta la semana epidemiológica 24 del año 2023 en Colombia se han notificado 1,860 casos por leishmaniasis cutánea, La incidencia acumulada nacional es de 18.88 casos por 100.000 habitantes en riesgo, según la población a riesgo suministrada por el Ministerio de Salud y Protección social.

En el período de estudio el evento fue predominante en hombres (71,88 %), en personas afiliadas a régimen subsidiado (63,49 %), de procedencia rural (80,86 %). Las lesiones se ubicaron en mayor medida en miembros inferiores (43,87 %), seguida por miembros superiores (43,71 %), cara (17,10 %) y tronco (13,98%)
El grupo de edad más afectado fue el de 20 a 29 años, lo cual concuerda con el comportamiento histórico. Es de resaltar que más del 70,0 % de los casos corresponden a menores de 40 años, lo que concuerda con los distintos reportes nacionales e internacionales que describen una mayor afectación en población en edad productiva(1)(fig. 3)


EN COLOMBIA:
Fuente: Organización Mundial de la Salud (OMS). Reporte de situación del brote mundial de mpox. Fecha de publicación: 24 de junio de 2023. Fecha de consulta: 29 de junio de 2023. Disponible en:
Casos de VIH: durante el periodo epidemiológico III de 2023, se han notificado 4,716 casos de VIH en Colombia. Las tasas de notificación de casos confirmados de VIH/SIDA es de 11,4 por 100.000 habitantes, y la tasa de incidencia es de 8,7 por 100,000 habitantes.


Grupos de riesgo: se ha identificado grupos específicos con mayor prevalencia de VIH:
Personas que se inyectan drogas(PID): representan el 2 % de los casos. Mineros y canteros tienen una proporción significativa.

Coinfección por COVID-19
Se ve que hay una relación entre los casos de VIH/SIDA y la pandemia de COVID-19 en Colombia durante el mismo periodo epidemiológico.
En el período epidemiológico actual (semanas epidemiológicas 22 a 25), en Colombia se han confirmado por laboratorio 2 973 casos nuevos por COVID-19 en 32 entidades territoriales del orden departamental y distrital, afectando 218 municipios. Durante este periodo se registró una incidencia de 6,57 casos por cada 100 000 habitantes; este indicador comparado con el periodo anterior (semanas epidemiológicas 18 a 21 de 2023) no presenta comportamientos inusuales a nivel nacional;

sin embargo, se identifica un incremento no significativo de la incidencia en 6 entidades territoriales. Los departamentos y distritos que durante este periodo superaron la incidencia nacional fueron: Bogotá; Arauca; Cali; Barranquilla; Antioquia; Boyacá; Casanare y Santander.
Fuente: Organización Mundial de la Salud (OMS). Reporte de situación del brote mundial de mpox. Fecha de publicación: 24 de junio de 2023. Fecha de consulta: 29 de junio de 2023.

Vásquez, S.T. et al. (2020). Afectación renal por Leishmania en paciente con infección por el VIH y el VHB no conocida. NefroPlus.12 (02). 90-94. https://www.revistanefrologia.com/es-afectacion-renal-por-leishmaniapaciente-articuloX1888970020006660#:~:text=La%20mayor%C3%ADa%20de%20los%20paci entes,aguda%2C%20glomerulonefritis%20o%20nefropat%C3%ADa%20cr%C3 %B3nica
Pereira, Á., & Pérez, M. (2002). Leishmaniosis. Offarm, 21(9), 116–124. https://www.elsevier.es/es-revista-offarm-4-articulo-leishmaniosis-13038008 Leishmaniasis. (n.d.). Medlineplus.gov. Retrieved May 13, 2024, from https://medlineplus.gov/spanish/ency/article/001386.htm
Virus del herpes simple. (n.d.). Who.int. Retrieved May 13, 2024, from https://www.who.int/es/news-room/fact-sheets/detail/herpes-simplex-virus Infecciones por estafilococos (2022, July 19) Mayo Clinic https://www.mayoclinic.org/es/diseases-conditions/staphinfections/symptoms-causes/syc-20356221 freepik, & Recursos, 14m. (n.d.). Ilustración de dibujo de riñón dibujado a mano. Freepik. Retrieved May 13, 2024, from https://www.freepik.es/vectorgratis/ilustracion-dibujo-rinon-dibujado-mano 143804322.htm
Nefrología, atención médica para problemas renales. Riñones aislados sobre fondo claro, dolor renal, quistes renales, insuficiencia renal, cáncer. Donante de órganos, mano sostiene riñones digitales. (n.d.). Adobe Stock. Retrieved May 13, 2024, from https://stock.adobe.com/co/images/nefrologia-atencion-medicapara-problemas-renales-rinones-aislados-sobre-fondo-claro-dolor-renalquistes-renales-insuficiencia-renal-cancer-donante-de-organos-manosostiene-rinones-digitales/540156807
(N d -c) Smiletemplates com Retrieved May 13, 2024, from https://es.smiletemplates.com/powerpointtemplates/kidney/07755/#google_vignette Vázquez Sánchez, T., Ortega Junco, E., Moliz Cordón, C., León Fradejas, M., Prieto Sánchez, E., & Hernández, D. (2020). Afectación renal por Leishmania en paciente con infección por el VIH y el VHB no conocida. Nefrologia: publicacion oficial de la Sociedad Espanola Nefrologia, 12(02), 90–94. https://www.revistanefrologia.com/es-afectacion-renal-por-leishmaniapaciente-articulo-X1888970020006660

Infección por citomegalovirus. (2022, May 18). Mayo Clinic. https://www.mayoclinic.org/es/diseases-conditions/cmv/symptomscauses/syc-20355358
Kaye, K. M. (n.d.). Infección por el virus herpes simple (HSV). Manual MSD versión para profesionales. Retrieved May 13, 2024, from https://www.msdmanuals.com/es-co/professional/enfermedadesinfecciosas/virus-herpes/infecci%C3%B3n-por-el-virus-herpes-simple-hsv (N.d.-e). Gov.Co. Retrieved May 13, 2024, from https://www.ins.gov.co/buscadoreventos/BoletinEpidemiologico/2023_Bolet%C3%ADn_epidemiologico_sema na _25.pdf
